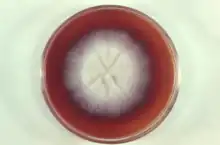

| Microsporum gallinae | |
|---|---|
| |
| Microsporum gallinae colony growing in petri dish | |
| Scientific classification | |
| Domain: | Eukaryota |
| Kingdom: | Fungi |
| Division: | Ascomycota |
| Class: | Eurotiomycetes |
| Order: | Onygenales |
| Family: | Arthrodermataceae |
| Genus: | Microsporum |
| Species: | M. gallinae |
| Binomial name | |
| Microsporum gallinae (Mégnin ex Guéguen) Grigorakis (1929) | |
| Synonyms | |
|
Epidermophyton gallinae Mégnin (1881) | |
Microsporum gallinae is a fungus of the genus Microsporum that causes dermatophytosis, commonly known as ringworm.[1] Chickens represent the host population of Microsporum gallinae but its opportunistic nature allows it to enter other populations of fowl, mice, squirrels, cats,[2] dogs and monkeys.[3] Human cases of M. gallinae are rare, and usually mild, non-life-threatening superficial infections.[2]
Taxonomy and naming
Microsporum gallinae was first identified in 1881 by Megnin from chicken favus,[4] and named Epidermophyton gallinae.[5] It was later transferred from the Epidermophyton genus, and classified in the Trichophyton genus, as T. gallinae.[4]
The identification of rough-walled macroconidia, a hallmark of the Microsporum genus, lead to the dermatophyte being classified as M. gallinae.[1][4] There is still debate about the phylogenetic placement of this dermatophyte, but the accepted name is Microsporum gallinae.[5] Analysis of its DNA sequences by PCR shows M. gallinae is most closely related to Microsporum vanbreuseghemii and Arthroderma grubyi, both are also zoophilic fungi.[3][6]
Distribution
Microsporum gallinae is distributed throughout the world, with cases reported in: Europe, the Middle East, South America, North America, Africa and Japan.[2] The fungus seems to be isolated more often in areas with high humidity and temperature.[3]
Morphology
In culture, M. gallinae produces a white, satiny colony.[7][8] The colony appears flat with radial folds and irregular edges as it grows in culture[7] The colony reverse produces a strong pigmentation that changes from pink to a deep red and diffuses through the growth medium.[5][7][8] Optimal growth of M. gallinae occurs at 26-28 °C,[3] and no special nutritional requirements are necessary for its growth.[9] Additionally, M. gallinae is urease positive.[9]
During sporulation, septate hyphae,[2][7] with macroconidia with tappered tips, and club shaped microconidia are present.[7][8][10] The addition of thiamine or yeast extracts promotes sporulation of M. gallinae.[7] Hair invasion observed in M. gallinae is large spored ectothrix type, meaning that the spores form outside of the hair shaft.[5]
Pathogenicity
Microsporum gallinae is a cosmopolitan zoophilic fungi that very rarely affects humans.[10] It obtains nutrients from keratin-rich skin, nails and hair, releasing enzymes during its digestion that elicit a host immune response as seen in ringworm.[11][12] Microsporum gallinae infection is diagnosed by culturing the scrapings from skin lesions.[9]
Chickens
Microsporum gallinae causes a superficial infection[13] that forms white lesions on the wattles and combs of chickens.[1][10] Lesions may spread to the head and neck.[2] The feathers are normally not affected by the dermatophyte, although some feather loss can occur.[1] Roosters and chicks tend to be more susceptible to the infection, with fighting cocks having the highest rates of M. gallinae dermatophytosis.[2] Although, it tends to resolve with treatment, the M. gallinae infection may become chronic.[1] The lesions can also become infected with bacteria, complicating the infection.[1] In some cases, it can resolve naturally without treatment; however, the infection may persist for weeks prior to clearance.[5]
Humans
Microsporum gallinae has been isolated from the scalp, and smooth skin in human populations.[10] Microsporum gallinae infections are most commonly tinea capitis and tinea corporis.[3] Very few human cases of M. gallinae infection have been reported, none of which were life-threatening.[9] Of the reported cases, individuals ranged from 3–96 years old.[3] They had cutaneous lesions on the glabrous skin or the scalp.[3] These localized lesions are frequently accompanied by itching.[2][9] The cutaneous manifestations are very similar to those of Microsporum canis therefore many cases of Microsporum gallinae could have been unreported.[3]
In rare cases, immunocompromised individuals form severe dissemination on the skin, instead of small localized lesions[3] as a result of handling infected animals.[2][9] Only one case of extensive dermatophytosis was reported involving M. gallinae infection of a person with AIDS.[2][3][9]
Treatment
The treatment of M. gallinae involves both topical and oral antifungals.[1][3] Topical antifungals, such as: Terbinafine,[3] Tolnaftate,[1] and orally administered Griseofulvin[1][9] have been used successfully to treat M. gallinae infections in humans and animals.
References
- 1 2 3 4 5 6 7 8 9 Fonseca, Edwin; Leonel Mendoza (1984). "Favus in a Fighting Cock Caused by Microsporum gallinae". Avian Diseases. 28 (3): 737–741. doi:10.2307/1590243. JSTOR 1590243. PMID 6487194.
- 1 2 3 4 5 6 7 8 9 Murata, Michiko; Hideo Takahashi; Sana Takahashi; Yoko Takahashi; Hiroji Chibana; Yoshiteru Murata; Kazutoshi Sugiyama; Takashi Kaneshima; Sayaka Yamaguchi; Hitona Miyasato; Masaru Murakami; Rui Kano; Atsuhiko Hasegawa; Hiroshi Uezato; Atsushi Hosokawa; Ayako Sano (2013). "Isolation of Microsporum gallinae from a fighting cock in Japan". Medical Mycology. 51 (2): 144–149. doi:10.3109/13693786.2012.701766. PMID 22809243.
- 1 2 3 4 5 6 7 8 9 10 11 12 Miyasato; Yamaguchi; Taira; Hosokawa; Kayo; Sano; Uezato; Takahashi (2011). "Tinea corporis caused by Microsporum gallinae: First clinical case in Japan". The Journal of Dermatology. 38 (5): 473–478. doi:10.1111/j.1346-8138.2010.01090.x. PMID 21352324. S2CID 20249376.
- 1 2 3 Silva, Margarita; Benham, Rhoda W. (December 1952). "Nutritional Studies of the Dermatophytes with Special Reference to Trichophyton Megnini Blanchard 1896 and Trichophyton Gallinae (Megnin 1881)". The Journal of Investigative Dermatology. 18 (6): 285. doi:10.1038/jid.1952.55.
- 1 2 3 4 5 TORRES, GLADYS; Georg, Lucille K. (1956). "A Human Case of Trichophyton Gallinae Infection". AMA Archives of Dermatology. 74 (2): 191. doi:10.1001/archderm.1956.01550080077011. PMID 13353992.
- ↑ Gräser, Y; el Fari, M; Presber, W; Sterry, W; Tietz, HJ (April 1998). "Identification of common dermatophytes (Trichophyton, Microsporum, Epidermophyton) using polymerase chain reactions". The British Journal of Dermatology. 138 (4): 576–82. doi:10.1046/j.1365-2133.1998.02165.x. PMID 9640360. S2CID 8176357.
- 1 2 3 4 5 6 Howard, D.H (2002). Pathogenic Fungi in Humans and Animals (2nd ed.). CRC Press.
- 1 2 3 Campbell, C, E and D.W; Johnson; Warnock (2013). Identification of Pathogenic Fungi (2nd ed.). Wiley Blackwell.
{{cite book}}: CS1 maint: multiple names: authors list (link) - 1 2 3 4 5 6 7 8 Del Palacio, A (1992). "Widespread dermatophyosis due to Microsporum gallinae in a patient with AIDS-a case report from Spain". Clinical and Experimental Dermatology. 6 (17): 449–453.
- 1 2 3 4 Kwon-Chung, K.J.; Bennet, E.J. (1992). Medical Mycology (2nd ed.). Lea & Febiger.
- ↑ Babel, Dennis E.; Rogers, Alvin L. (June 1983). "Dermatophytes: Their contribution to infectious disease in North America". Clinical Microbiology Newsletter. 5 (12): 81–85. doi:10.1016/S0196-4399(83)80014-2.
- ↑ Weitzman, I; Summerbell, R.C. (April 1995). "The dermatophytes". Clin Microbiol Rev. 8 (2): 240–259. doi:10.1128/cmr.8.2.240. PMC 172857. PMID 7621400.
- ↑ Aurora, Dilip K.; Libero Ajello; K.G.Mukerji, eds. (1991). Handbook of applied mycology. New York: Marcel Dekker. ISBN 0824784359.